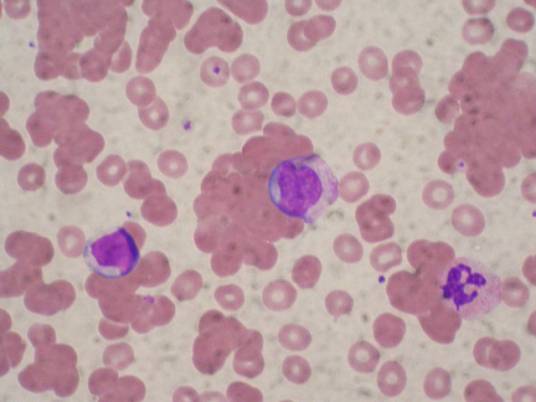
冷凝集

冷凝集
的有关信息介绍如下:
冷凝集是指人体被支原体感染以后,血清中产生的高滴度的寒冷凝集素。这种凝集素能和自己体内的红细胞或O型血人的红细胞,在0-4℃寒冷情况下产生凝集现象。而冷凝集现象则一般通过冷凝集试验,运用于测试原发性非典型性肺炎。
想要了解更多“冷凝集”的信息,请点击:冷凝集百科
冷凝集是指人体被支原体感染以后,血清中产生的高滴度的寒冷凝集素。这种凝集素能和自己体内的红细胞或O型血人的红细胞,在0-4℃寒冷情况下产生凝集现象。而冷凝集现象则一般通过冷凝集试验,运用于测试原发性非典型性肺炎。
想要了解更多“冷凝集”的信息,请点击:冷凝集百科